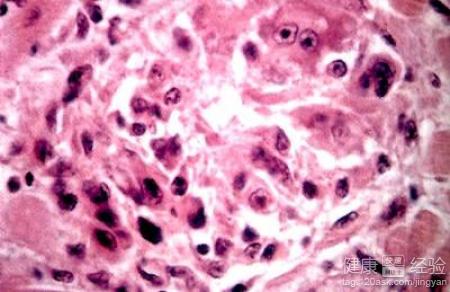
第3步

心髒病是一類比較常見的循環系統疾病,也成為心血管疾病,這個疾病嚴重影響到患者的生活以及勞動力;主要包括風濕性心髒病、先天性心髒病、高血壓性心髒病、冠心病、心肌炎等各種心髒病。這個疾病可以發生在任何年齡段的任何人群,所以這個疾病對人類的健康的影響是十分重大,所以要盡早的認識疾病後積極的進行相關預防,我們今天要來認識的是心髒病中一種比較常見的類型---風心病。
1風心病是風濕性心髒病的簡稱,從這個字面上意思了解是由於風濕熱這個疾病引起心髒方面出現問題的一種疾病類型,事實上風濕性心髒病這個疾病也就是由於風濕熱活動的時候累積到心髒瓣膜從而造成的心髒瓣膜病變的一種疾病。
2心髒瓣膜有二尖瓣,三尖瓣,主動脈瓣,肺動脈瓣,而風濕性心髒病主要是由於疾病累及到二尖瓣,三尖瓣,主動脈瓣其中的一個或者幾個從而引起瓣膜關閉不全或者狹窄的情況出現引起的臨床表現就稱為風濕性心髒病。

3風濕性心髒病一般引起的常見致病菌是甲組乙型溶血性鏈球菌引起的變態反應的表現,屬於自身免疫性疾病,一般最常見累及到的心髒瓣膜是二尖瓣,所以一般會導致左心房壓力增高,形成肺淤血的情況。
風濕性心髒病是一種自身免疫性疾病類型,一般可以通過防止上呼吸道感染誘發風濕活動那麼就可以避免加重病情的出現,同時在生活中可以適當的運動,平時要限制鈉鹽的攝入,盡早都進行相關治療。